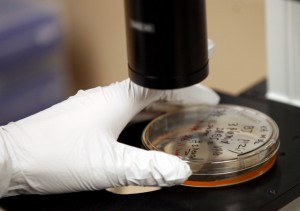
npr-interview-image

National Public Radio (NPR) Air Talk: Doctors, patients pressure FDA to regulate commercial stem cell clinics
“We would have to setup a study for knee arthritis, for shoulder arthritis, for every condition that exists. There’s no drug that exists that has a claim for everything it cures. We believe you need to get the data. We have a large registry. In fact, we’ve offered to let the FDA use our registry or something similar to it. It’s very interesting, innovation is not driven by academia”. –Mark Berman, MD, FACS
Click here to read article

